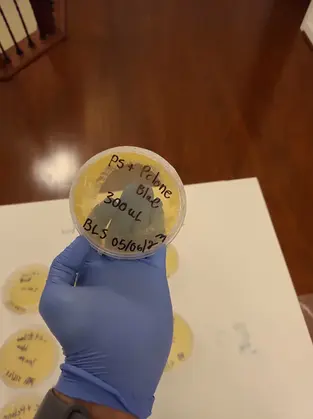
bece30_fc6e37f449564946bce61416c2646714~mv2

DMV Petri Dish Welcomes You
Nurturing Investigation
Elevating your side projects!
Our method of ‘vertically integrated’ incubation develops ideas from start to finish. We develop passionate community members from all walks of life into scientists and entrepreneurs. We expand the skillsets of existing professionals so they may pursue their dream projects. We provide our community with the tools and opportunities they need to take their ideas from the backside of a napkin and into the real world.
As a non-profit, DMV Petri Dish fosters innovation in the DC metro area by injecting research, education, and startup development into a powerful community of inventors, scientists, developers, investors, non-profits, and biotech companies. We foster innovation in our community by harnessing the grassroots energy from the plethora of local technology enthusiasts and connecting it to established biotech insiders that work at some of the nation’s most venerated research and development institutions. Our community ideates, and we turn their side projects into meaningful research programs that drive innovation.

The programs developed and offered by DMV Petri Dish are a perfect fit for everyone interested in science, tech, and entrepreneurship! We believe the projects that the enthusiasts in our community develop in their own time are key to innovation in the DC Metro Area, and we look to infuse these projects into the usual things we relate with innovation. Our ‘Borromean Doctrine‘ uses these innovative side projects to drive education and workforce development, research and development, and startup incubation.
Meetups and Networking
Contact us

